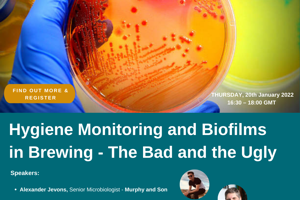

Library
 CIBD Membership Required
CIBD Membership Required
Current Research in Brewing and Distilling
By: Rutele Marciulionyte, Joel Saunderson, Alan Philp, Barnaby Pownall, Sally MacGarry
23/02/2023
Learn about the latest research taking place in the drinks industry in Scotland. Five speakers from Heriot-Watt University have been invited to give short talks on the current state of their research, into varied themes across the brewing and distilling sector. Sensory science, yeast and fungal microbiology, and the impact of process and raw materials on the production of beer and whisky are the key themes of the talks.
 Open Access
Open Access
El Mito sobre el First Wort Hopping
31/01/2023
Descubre la técnica de First Wort Hopping (FWH), o lupulado en primer mosto en este segundo webinar en español que organiza el IBD. Presentado por Ricardo Solis, Learning Partner del IBD en Hispanoamerica y Johann Bertazzoni, Key Account Manager para el sector craft de la Cooperativa Productores de Lúpulo Alemán (HVG). Maestro Cervecero egresado de la TUM (Weihenstephan), Diploma Biersommelier de la Academia Doemens.
 CIBD Membership Required
CIBD Membership Required
Novalager y Biotransformación del Lúpulo
By: Ricardo Solis, Mariano Tissone
06/12/2022
La sección Internacional ofrecerá información actualizada y relevante a los cerveceros de habla hispana sobre la innovación en levaduras para elaborar cervezas lager, y su interacción con el lúpulo en fermentación.
 CIBD Membership Required
CIBD Membership Required
Bioarchaeology of Ancient Beers
10/11/2022
Find out why analysing past beers might be potentially beneficial for future beer design at our latest webinar hosted by the IBD Great Northern section, followed by a Q&A session with an expert.
 CIBD Membership Required
CIBD Membership Required
Sensory Perception of Whisky Flavour
By: Dr Irene Baxter
07/07/2022
Discover the mechanisms of flavour in relation to Scotch Whisky with Dr Irene Baxter, Sensory Scientist at The Scotch Whisky Research Institute.
 CIBD Membership Required
CIBD Membership Required
Sustainable Innovation in the Drinks Industry
By: Michaela Appelbee-Miedl, Steffen Müench, David Thompson, Tom Mellor, Jamie Robertson
28/04/2022
Discover the vital importance of finding ways to deploy sustainable innovation in the drinks industry. Innovation is vital for a company’s survival and growth. Firms that don’t innovate fall behind their competitors and ultimately go out of business. However, traditional forms of innovation may result in profitable products, services, and processes – but also harm employees or over-exploit natural resources.
International Section, sustainability, innovation, sustainable innovation
 CIBD Membership Required
CIBD Membership Required
Maillard Mash, Washback Microbiota & Mixed Fermentations
By: Rutele Marciulionyte, Hannah Proctor, Barnaby Pownall
03/02/2022
Learn from three PhD students from Heriot-Watt University about the latest whisky production research investigation on flavour, microbiota and washback ketones and brewing mixed culture fermentation. Presentation 1: Roasted malts for novel flavours in whisky production by Rutele Marciulionyte Presentation 2: The fungi, the ketones, and the washback: The influence of distillery microbiota on whisky flavour by Hannah Proctor Presentation 3: Exploring the potential and control of mixed culture fermentations in brewing by Barnaby Pownall
CIBD Membership Required
CIBD Membership Required
Hygiene Monitoring and Biofilms in Brewing - The Bad and the Ugly
20/01/2022
Take a deep dive into the fascinating field of hygiene and biofilms. This session recording is especially interesting for brewers, cider makers and distillers, and also for soft drinks and wine producers. Alexander Jevons, Senior Microbiologist at Murphy and Son, and Dr Keith Thomas, Director of Brewlab and founder of Darwin Brewery, both experts in the field, show us the consequences of poor CIP and lack of monitoring.
Some of the content requires an active membership to view.
You can find out more here
Some of the content requires an active membership to view.
You can find out more here
